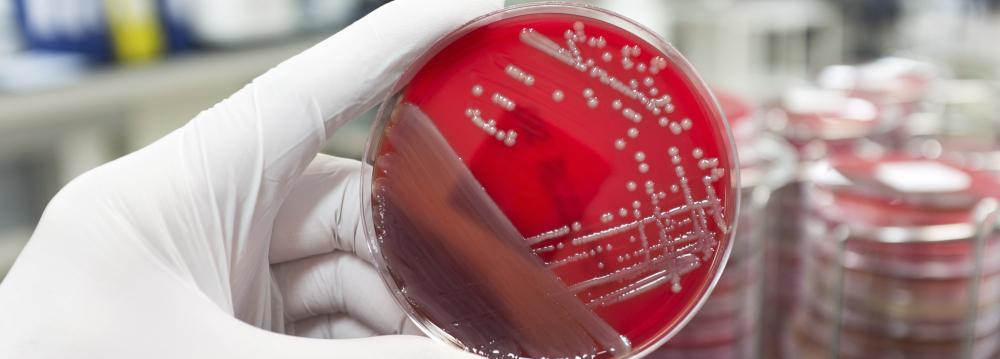

US health officials have reported the first case in the country of a patient with an infection resistant to a last-resort antibiotic, and expressed grave concern that the superbug could pose serious danger for routine infections if it spreads.
“We risk being in a post-antibiotic world,” said Thomas Frieden, director of the US Centers for Disease Control and Prevention, referring to the 49-year-old Pennsylvania woman who had not traveled in the prior five months.
Frieden, speaking at a National Press Club luncheon in Washington, said the bacteria was resistant to colistin, an antibiotic that is reserved for use against “nightmare bacteria.”
The infection was reported Thursday in a study appearing in Antimicrobial Agents and Chemotherapy, a publication of the American Society for Microbiology. It said the superbug itself had first been infected with a tiny piece of DNA called a plasmid, which passed along a gene called mcr-1 that confers resistance to colistin.
“(This) heralds the emergence of truly pan-drug resistant bacteria,” said the study, which was conducted by the Walter Reed National Military Medical Center. “To the best of our knowledge, this is the first report of mcr-1 in the US.”
The patient visited a clinic on April 26 with symptoms of a urinary tract infection, according to the study, which did not describe her current condition, Reuters reported.
“It is dangerous and we would assume it can spread quickly, even in a hospital environment if it is not well contained,” said Dr. Gail Cassell, a microbiologist and senior lecturer at Harvard Medical School.
But she said the potential speed of its spread will not be known until more is learned about how the Pennsylvania patient was infected, and to what extent the colistin-resistant superbug is present in the US and globally.
In the US, antibiotic resistance has been blamed for at least 2 million illnesses and 23,000 deaths annually.
The potential for the superbug to spread from animals to people is a major concern, Cassell said.
For now people can best protect themselves from it and from other bacteria resistant to antibiotics by thoroughly washing their hands, washing fruits and vegetables thoroughly and preparing foods appropriately.
Frieden said the need for new antibiotics is one of the more urgent health problems, as bugs become more and more resistant to current treatments. “The more we look at drug resistance, the more concerned we are. The medicine cabinet is empty for some patients. It is the end of the road for antibiotics unless we act urgently.”
Overprescribing of antibiotics by physicians and in hospitals and their extensive use in food livestock have contributed to the crisis. More than half of all hospitalized patients get an antibiotic at some point during their stay. Studies have shown that 30% to 50% of antibiotics prescribed in hospitals are unnecessary or incorrect, contributing to antibiotic resistance.